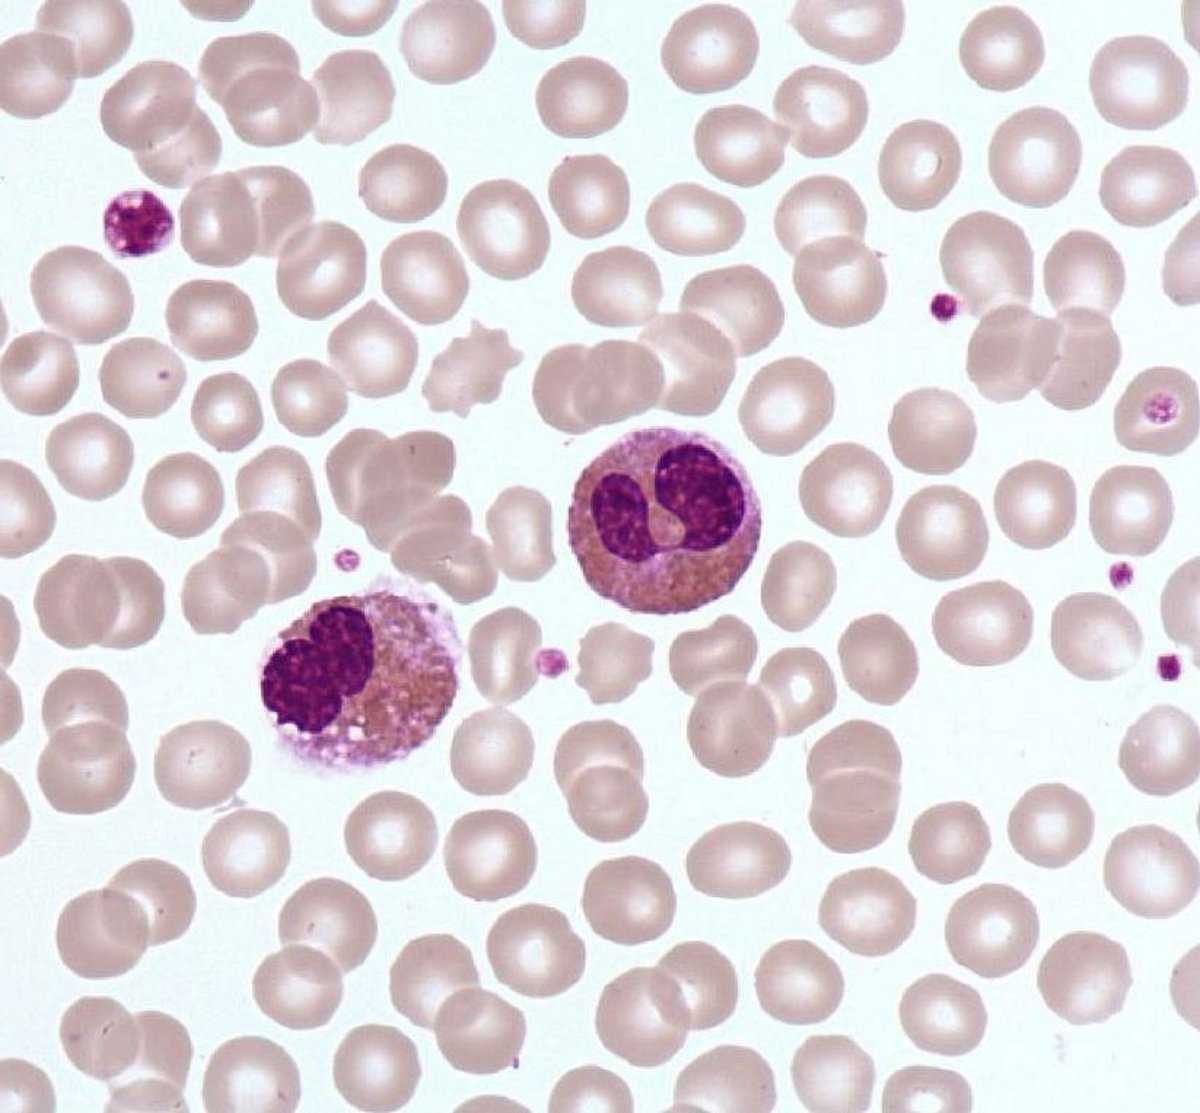
Eosinophil_polymorphonuclear Eosinophil_polymorphonuclear

Medium size round cell, bilobed (wallet appearence) nucleus with a condensed chromatin, unstained cytoplasm covered with very large eosinophilic granules packed together (bead bag appearance).
The large orange granules of the eosinophil make this cell well recognizable in the blood. These specific granules are known to be toxic to several parasites (helminths, microfilariae; schistosomiasis), and some mammalian cells.
Hypereosinophilia in parasitosis and allergic reactions.
Hypereosinophilia in the Primitive Hypereosinophilic Syndrome : increased number with abnormalities ( hypogranulation, fines granules, often associated to a recurrent molecular abnormality; the most frequent is the FIP1L1-PDGFRa)
Hypereosinophilia can be associated with hematological malignancies: T-cell lymphoma, Hodgkin's disease, Chronic Myeloid Leukemia.